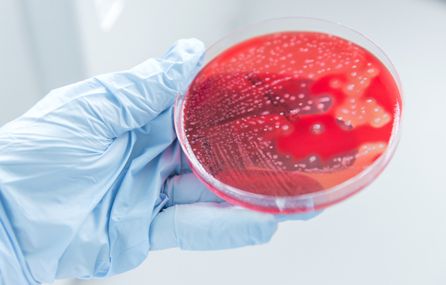

BBSRC Doctoral Training Partnership
We regret that this Programme is no longer open to new applicants. We are not recruiting for 2024/2025.
The Imperial College London-Royal Holloway BBSRC Doctoral Training Partnership (DTP) supports multidisciplinary and cross disciplinary postgraduate research training in the modern biosciences.
Remaining 2019 Projects
Our Programme
Our unique DTP programme offers an intensive, student-centered training programme in which research students pursue a Masters course en route to the PhD programme. This 1+3 training programme is structured so students are enrolled in a relevant Masters course at either institution in the first year before commencing the PhD project for the remaining three years. The Masters-level course is determined by the student and the joint supervisors at time of programme selection. This rigorous, first-year training provides students with a customised mix of quantitative and research skills to best prepare the student to undertake the PhD research projects. In instances where a student already has a relevant Masters or equivalent training, the +3 programme would be a suitable option.
During the PhD programme, students work on a specific PhD project with two supervisors often from different departments and institutions. In so doing, the student will both experience two ways of thinking as well as two sets of skills in one working on the project. The programme further affords students the opportunity to develop their research and quantiative skills and interests through a student-centered programme that provides robust mathematical and computational training in order to advance knowledge across a broad range of problems in the biosciences.
Our DTP programme leverages the strengths and acumen of Imperial College and Royal Holloway to deliver a cohort of scientists with the necessary training to address major social and economic challenges as linked to the key Strategic Priorities identified by the BBSRC. All of our projects are underpinned by Exploiting New Ways of Working, which promotes innovative working practices in an era of rapid technological advancement. Our PhD projects span all the BBSRC Strategic Priority Areas:



.jpg)
-(1).jpg)